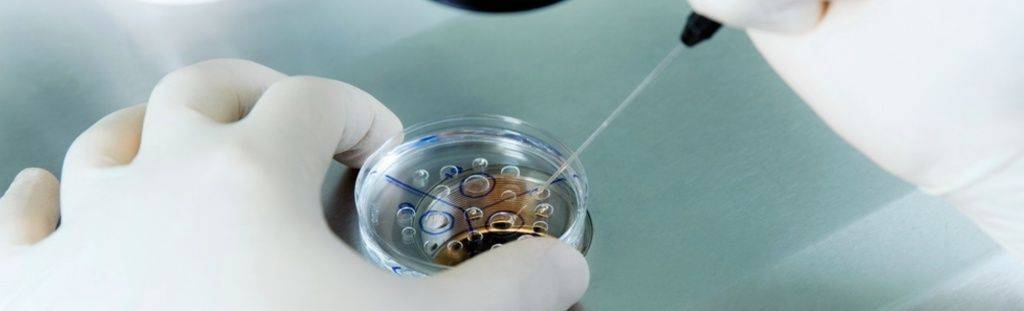

Профилактические меры
Чтобы не допустить развития каких-либо патологий во время беременности, в том числе и нарушения кровотока, женщинам в положении нужно избегать негативных эмоций, физических перенапряжений и стрессовых ситуаций
Важно исключить вредные привычки. Нужно следить за питанием, включить в ежедневный рацион злаки, фрукты, зелень, овощи и орехи
Полезными будут регулярные прогулки на свежем воздухе и занятия гимнастикой для беременных. Спать нужно на левом боку. Комфортные условия во время ночного и дневного отдыха обеспечит U-образная подушка для беременных и кормящих «Body Pillow».
Этап переноса эмбрионов: условия и техника процедуры
Поскольку перенос эмбрионов при ЭКО — процесс неинвазивный, методика его осуществления не предполагает обезболивания (возможно использование спазмолитика). В проведении процедуры участвуют два доктора: эмбриолог и гинеколог-репродуктолог. Основным инструментом является атравматичный силиконовый катетер, деликатно проходящий шейку матки.
Процедура, выполняемая репродуктологом, происходит под ультразвуковым контролем. Врач и пациентка видят на дисплее компьютера продвижение катетера и выделение его содержимого — микрокапли, в которой находятся имплантируемые эмбрионы.
Вся манипуляция длится не дольше 10 минут: необходимо, чтобы эмбрионы как можно меньше находились вне инкубатора. Ощущения пациенток в редких случаях могут быть неприятными, но на боли они никогда не жалуются.
Как готовиться к переносу эмбрионов: пошаговая инструкция
- За час до манипуляции выпить 1 литр воды. В меру наполнив мочевой пузырь, жидкость обеспечит технике исполнения переноса точность, деликатность и успешность.
- Перед походом в клинику принять душ, после чего не использовать косметику и парфюм.
- За 15 минут до решающего момента постараться успокоиться, прогнать страхи и настроиться на позитивный лад.
Ход процедуры
- После обработки области шейки матки стерильным марлевым шариком репродуктолог осуществляет пробный перенос. Во влагалище вводится пустой катетер для того, чтобы убедиться в проходимости канала. Кроме того, это необходимо для установления на катетрой трубке ограничителя длины в сответствии с протяженностью цервикального канала.
- Эмбриолог под микроскопом набирает в катетер питательную среду с отобранными эмбрионами. На микроскопе есть камера, с помощью которой этот процесс визуализируется на мониторе, становясь наглядным для репродуктолога и пациентки.
- Эмбриолог передает подготовленный катетер репродуктологу. Тот вводит его в верхнюю треть полости матки (не доходя 10-15 мм до ее дна) и плавным нажатием на поршень впрыскивает эмбрионы, после чего аккуратно извлекает инструмент.
- Катетер снова передается эмбриологу, который проверяет его под микроскопом, продувая несколько раз воздухом. Так убеждаются в том, что эмбрионы остались в матке.
- После процедуры в продолжение примерно получаса пациентка остается на гинекологической кровати под врачебным наблюдением. Затем ей разрешается покинуть клинику на 2 недели — до момента проведения теста на беременность.
Главное, что интересует женщину после переноса эмбриона: когда он должен прижиться? На этот вопрос репродуктологи отвечают, что период “имплантационного окна” длится не более 48 часов. Но для его открытия потребуются совместные усилия врача и пациентки.
Как нарастить
Поскольку эндометрий при переносе эмбриона определяет, насколько будет успешной процедура экстракорпорального оплодотворения, если толщина выстилающего слоя недостаточная, необходимо провести лечебные мероприятия, направленные на ее увеличение. В большинстве случаев предпочтение отдается терапии гормонального типа.
При этом лекарственные препараты необходимо пить в период подготовки к беременности, и после ее наступления, что позволит избежать самопроизвольного выкидыша. Также в некоторых случаях медикаменты гормональной группы прописывают женщинам, которые смогли зачать ребенка естественным путем, в целях сохранения беременности.
Зная о том, что норма эндометрия при ЭКО составляет 7 мм, женщины задаются вопросом, почему его необходимо наращивать именно гормональными препаратами. Дело в том, что истончение выстилающего слоя матки, в большинстве случаев, диагностируется на фоне нарушений в работе эндокринной системы и некорректной выработки половых гормонов.
Непосредственно перед началом лечения женщина, которой будет проводиться экстракорпоральное оплодотворение, должна будет сдать анализ крови и мочи, по результатам которых будет определено, какие вещества находятся в недостатке, а какие в избытке. Благодаря этим данным медик подберет наиболее подходящую терапию.
Эстрогены
Разбираясь с таким непростым вопросом, как улучшить эндометрий перед ЭКО, необходимо понять, что важно провести тщательную подготовку организма к процедуре. Для этого пациентке при планировании беременности назначают препараты, в составе которых имеются эстрогены. Наиболее известными и популярными из них считается Прогинова и Эстрофем
Наиболее известными и популярными из них считается Прогинова и Эстрофем.
Также не стоит пренебрегать и гормональной терапией местного типа, при которой используются гели и мази, например, Давигель или Эстрожен. Однако такой способ решения проблемы практикуется в крайне редких случаях, поскольку количество гормонов в этих препаратах очень низкое. Наиболее подходящую дозу определяет ведущий специалист, основываясь на том, каких именно веществ не хватает, какая была исходная толщина эндометрия, а также с учетом возраста пациентки.
Нередко случается так, то нормальная толщина для переноса эмбрионов достигается лишь после полугода такой терапии, поэтому женщине необходимо набраться терпения.
Прогестерон
Препараты, в составе которых имеется прогестерон, назначаются непосредственно для того, чтобы нарастить толщину выстилающего слоя матки. Именно это вещество запустит процесс активного деления клеток, будет контролировать процесс обновления и восстановления слизистого слоя.
Поскольку толщина эндометрия при переносе эмбрионов в идеале должна составлять 7 мм, для достижения этих показателей во втором цикле медикаментозной терапии назначается прогестерон, но прием эстрогена не прекращается. Собственно, это вещество будет подготавливать слизистую оболочку к тому, что будет произведена имплантация плодного яйца. Зачастую женщинам назначают Утрожестан, Крайнон или Ипрожин.
Стоит отметить, что медикаменты, в составе которых имеется прогестерон, также рекомендуется принимать и в течение всей беременности, особенно, на первых неделях развития плода, поскольку вещество регулирует тонус матки. Именно поэтому прогестерон первый триместр принимают не только женщины, забеременевшие после ЭКО, но и естественным путем.
Другое
Зная о том, какой должен быть эндометрий при ЭКО, а также какими медикаментами можно нарастить толщину слоя, необходимо сказать, что причиной истончения слизистого слоя, может быть и плохое кровообращение в выстилающих тканях. Чтобы стабилизировать это состояние пациенткам назначают такие лекарства как Актовегин, Кортексин, Нобен, Диваза, Мексидол.
Определенное внимание стоит уделить также балансу витаминов и минералов в организме, поскольку. Если их будет слишком много, или, наоборот, мало, это также может сказаться на состоянии эндометрия. Практически всем женщинам перед экстракорпоральным оплодотворением проводится витаминотерапия
Практически всем женщинам перед экстракорпоральным оплодотворением проводится витаминотерапия.
В частности, назначают вещества из группы B, дополняя их витаминами A, E, C. Благодаря этому можно значительно улучшить процесс циркуляции крови, ускорить регенерацию тканей, повысить местный и общий иммунитет. Что касается минералов, то организм, зачастую, нуждается в цинке, магнии и железе. Такие препараты могут вводить инъекционным способом или перорально, но обязательно курсом не менее двух недель.
Состав и механизм действия препарата «Дюфастон»
Прогестерон – половой гормон, отвечающий за менструальный цикл и беременность. Его недостаток приводит к ухудшению самочувствия женщины, сложностям с зачатием и вынашиванием ребенка, развитию гинекологических заболеваний. Дюфастон используется при нехватке гормона в организме и сопутствующих нарушениях уже более 3-х десятилетий. Главный действующий компонент медикамента – дидрогестерон. Вещество является синтетическим аналогом прогестерона, используется для восполнения дефицита этого гормона в организме.
В результате приема уровень вещества нормализуется, восстанавливается цикл, происходит овуляция, полость матки подготавливается к закреплению эмбриона. Препарат отвечает за подготовку женского организма к беременности, обеспечивает ее нормальное протекание и снижает риск развития патологий у плода. Он хорошо изучен и относительно безопасен, однако является рецептурным – необходимость приема, схему терапии и дозировку определяет лечащий врач.
Подготовка к процедуре ЭКО
- Отказаться от вредных привычек. Курение, употребление алкоголя и психоактивных препаратов негативно влияет на весь организм. В том числе на репродуктивную систему. В сигаретах, спиртных напитках, наркотиках содержится целый комплекс веществ, вызывающих клеточные мутации, интоксикацию и иные негативные последствия для здоровья. Даже в небольших дозах они способны нанести вред репродуктивной системе и снизить вероятность успешного зачатия. Более того, у женщин вредные привычки вызывают патологии, которые даже после наступления беременности провоцируют аномалии плода или делают невозможным вынашивание и рождение ребенка.
- Проверить вес тела. Недостаточная или избыточная масса нарушают нормальную работу как мужской, так и женской репродуктивной системы, отрицательно сказываются на качестве половых клеток. Для успешного оплодотворения необходимо контролировать индекс массы тела. Высчитать его можно, разделив вес (в кг) на квадрат роста (в м2) – допустимый интервал составляет 19-30 кг/м2. При выходе за пределы этих значений ЭКО лучше перенести до тех пор, пока индекс массы тела не вернется к нормальным значениям. Также необходимо пройти медобследование, чтобы выявить возможные эндокринные, психические и другие патологии, спровоцировавшие проблемы с весом.
- Придерживаться принципов здорового питания. Для успешного зачатия оба родителя должны получать весь комплекс питательных веществ – белки, жиры, витамины, углеводы, жирные кислоты и т. д. Поэтому перед ЭКО противопоказано соблюдение строгих и монодиет, употребление продуктов с большим количеством пищевых добавок, заменителей, растительных трансжиров. Рекомендуется включить в рацион свежие овощи и фрукты, морскую рыбу, запеченное или приготовленное на пару нежирное мясо (курицу, говядину), кисломолочные продукты.
- Принимать витаминно-минеральные комплексы. В период беременности и вынашивания плода женскому организму необходимы такие витамины, как В6 и В12, фолиевая кислота – без них возрастает вероятность развития детских патологий у плода. Также полезно увеличить потребление кальция, цинка, магния, фосфора, железа и других минералов. Точную дозировку должен назначить врач-диетолог, так как гипервитаминоз также может быть опасен для матери и ее ребенка, как и недостаток биологически-активных веществ.
- Вести активный образ жизни. Обоим будущим родителям рекомендуется увеличить физическую активность – это укрепляет организм и помогает справиться со стрессом. Однако, для женщины в период проведения ЭКО противопоказаны большие нагрузки, поэтому лучше выполнять легкие упражнения по 30-40 минут в день 3-4 раза в неделю. Хорошо подойдет легкий бег, пилатес, йога или простая прогулка на свежем воздухе.
- Сделать прививки. Некоторые бактериальные и вирусные инфекции (герпес, грипп, краснуха и т. д.) в пренатальный период способны вызвать генетические отклонения у плода. Перед ЭКО женщине необходимо пройти обследования на эти заболевания и, при отсутствии иммунитета к ним, сделать прививки. Также, при наличии хронических заболеваний, рекомендуется проконсультироваться с врачом, чтобы он скорректировал курс лечения и предложил наиболее оптимальный протокол ЭКО с учетом всех рисков для матери и ребенка.
- Ограничить сексуальную активность. Подготовка к ЭКО не оказывает значительного влияния на половую жизнь будущих родителей. Однако, им обоим стоит отказаться от всякой сексуальной активности за 3-4 дня до пункции фолликулов и в течение 7 дней после экстракорпорального оплодотворения. Это необходимо для получения достаточного количества спермы у мужчин и повышения вероятности успешного закрепления эмбриона в матке.
Вопрос-ответ:
Какие медикаментозные методы помогают подготовить эндометрий к ЭКО?
Для подготовки эндометрия к ЭКО применяются такие медикаментозные методы, как гормональная терапия, инъекции гонадотропина, лечение антибиотиками, витамины и минеральные добавки. Данные методы помогают создать условия для максимальной успешности оплодотворения после введения эмбриона.
Как важно выбирать физиотерапевтические методы для подготовки эндометрия к ЭКО?
Важность выбора правильных физиотерапевтических методов для подготовки эндометрия к ЭКО заключается в их эффективности и безопасности. Неверное применение методов может привести к негативным последствиям и повлиять на успешность процедуры
Как происходит подготовка эндометрия к ЭКО с помощью гормональной терапии?
Гормональная терапия для подготовки эндометрия к ЭКО происходит путем применения экзогенных гормонов, которые подавляют естественный цикл организма и создают условия для создания более благоприятных условий для оплодотворения. Это может включать в себя применение препаратов эстрогенов, прогестерона и гонадотропина, для обеспечения оптимального уровня гормонов в организме.
Как можно увеличить эффективность подготовки эндометрия к ЭКО?
Увеличить эффективность подготовки эндометрия к ЭКО можно, применяя комбинацию медикаментозных и физиотерапевтических методов, соблюдая правильный режим питания и сна, дополнительно употребляя полезные витамины и минералы
Также важно осуществлять контроль за состоянием организма и своевременно ликвидировать возникающие проблемы и осложнения
Насколько важна правильная подготовка эндометрия к ЭКО для успеха процедуры?
Правильная подготовка эндометрия к ЭКО играет ключевую роль в успехе процедуры, так как благоприятное окружение в утробе матери является важным фактором для оплодотворения и развития эмбриона. На успех процедуры также влияют многие другие факторы, однако корректно подготовленный эндометрий увеличивает шансы на положительный исход.
Физиолечение подбирается индивидуально, как и другие методы
Физиотерапевтические процедуры могут применяться по назначению врача в циклах, предшествующих протоколу ЭКО и непосредственно в самом протоколе.
Подбор физиотерапевтических методик осуществляется индивидуально для каждой пациентки и обязательно учитывает состояние полости матки и эндометрия (по данным результата гистероскопии и гистологического исследования эндометрия, УЗИ в динамике, допплерометрии);
важно установить в результате тщательного обследования преобладающий синдром (синдром воспаления, нарушение регенерации или микроциркуляции, дистрофический);
сопутствующие гинекологические и соматические заболевания;
сроки проведения попытки ЭКО (в данном цикле или в последующих).
Например, результативность использования магнитотерапии в 1,5 раза выше у пациенток с преобладанием воспалительных изменений в эндометрии, электротерапии — в 2 раза выше у больных с преобладанием соединительнотканных (фиброзных) изменений в эндометрии, что подтверждает необходимость выбора физического фактора с учетом причин и механизма развития патологического процесса*.
Большинство физиопроцедур проводится на фоне контрацепции, предпочтительна — барьерная (презерватив)
Контроль эффективности лечения, отмена контрацепции или использование ВРТ целесообразны только по завершении рекомендованных последовательных курсов физиолечения и рационального использования медикаментозных средств, поэтому крайне важно соблюдать все рекомендации курирующих докторов — врача-репродуктолога и физиотерапевта.
Самочувствие женщины после подсадки
Обычно имплантация происходит на седьмой день. Согласно статистике, наступление беременности бывает в 40 %. Первая неудача не должна обескураживать, поскольку повторные попытка значительно увеличивают шансы на успех.
В первые две недели состояние женщины может оставаться таким же, как и до проведения процедуры. Само закрепление эмбриона физически прочувствовать невозможно, до 14 дня не является информативным и проведение теста на беременность.
Некоторые жалуются на общее ухудшение самочувствия и ноющие боли внизу живота. Если ноет живот или тошнит, это может быть реакцией организма на назначенную медикаментозную поддержку. Могут возникать и другие ощущения, например, головокружение и слабость. Они не относятся к патологиям и являются естественным последствием проведения процедуры
В этих случаях женщине нужно обратить внимание на полноценное питание и проводить больше времени на свежем воздухе. Максимальный покой, ограничение физических нагрузок, крепкий сон в течение не менее 8 часов помогут устранить эти проявления. Первые достоверные признаки имплантации, которые свидетельствуют о том, что подсадка прошла успешно возникают по истечении двух недель, но некоторые из них в той или иной степени могут беспокоить и раньше
Первые достоверные признаки имплантации, которые свидетельствуют о том, что подсадка прошла успешно возникают по истечении двух недель, но некоторые из них в той или иной степени могут беспокоить и раньше.
Симптомы после переноса эмбрионов при ЭКО по дням:
- нагрубание молочных желез – 3-8 день;
- повышенная утомляемость, сонливость, апатия – 2-8 день;
- головные боли, головокружение, тошнота, иногда рвота – 2-7 день;
- проблемы с опорожнением кишечника, частое мочеиспускание – после 2 недель;
- изменение вкусовых предпочтений, запоры, метеоризм – через 14 дней;
- потемнение сосков, незначительные выделения из влагалища – через 2 недели;
- появление линии, идущей от пупка к лобку – 1-3 месяц.
Болезненная чувствительность груди возникает в результате мощного выброса прогестерона, который происходит на самых ранних сроках беременности. Это особенно заметно у женщин, которые испытывают такие же симптомы перед началом месячных.
Мажущие выделения после переноса эмбрионов иногда пугают женщину, а между тем, это один из признаков того, что процедура закончилась результативно. Закрепление зародыша провоцирует разрушение мелких сосудов, что и вызывает выделения. Они не должны иметь запаха и сопровождаться повышением температуры и зудом. Если возникающие выделения сильные, зловонные, имеют зеленый или серый цвет, нужно обратиться к врачу. Это может быть признаком отслоившегося плодного яйца.
Однако, даже наличие нескольких из перечисленных признаков не может абсолютно точно указывать на состоявшуюся беременность. Довольно часто они могут быть всего лишь предвестниками очередной менструации. Главное, на что ориентируются женщины и их врачи – это задержка месячных, анализ крови на ХГЧ и результаты первого УЗИ.
Многие женщины, испытывая понятное нетерпение, делают тест на определение беременности уже в первые дни появления ее симптомов. Однако, количество хорионического гонадотропина в этот период настолько мало, что даже чувствительный тест не покажет желаемые результаты. Достоверные данные можно получить не ранее, чем через две недели.
Для этого можно воспользоваться обычным тестом из аптеки, но предпочтительнее будет анализ уровня ХГЧ, сделанный в лабораторных условиях. Показатели в 100-150 МЕд/мл указывают на то, что имплантация прошла успешно. Уровень ХГЧ 50-70 Мед/мл дает основания к дальнейшему наблюдению и продолжению прогестероновой терапии. Более низкие показатели свидетельствуют о том, что беременность не состоялась, а результаты 200-300 Мед/мл указывают на многоплодие.
Почему эмбрионы после переноса не приживаются?
Причин того, что матка расценивает зародыш как инородное тело, от которого нужно избавиться, может быть несколько. Среди них наличие в матке миомы, предыдущие аборты, нарушения толщины эндометрия, недостаточный уровень прогестерона. Имплантация эмбриона не произойдет в случае наличия его генетических отклонений.
https://youtube.com/watch?v=xsr0B-QyGh8
Препятствием для имплантации могут быть лишний вес, возраст старше 45 лет, нарушения в работе иммунной системы. Если зародыш не прижился, у женщины начинается обычная менструация.
Могут ли возникнуть осложнения в процессе подсадки?
Специалисты не исключают подобную вероятность. Подобное может иметь место, если:
- Врачу не удается пройти цервикальный канал по причине имеющихся препятствий (изгибов, сращений). При таких обстоятельствах эмбрион потребуется поместить в жесткий катетер с проводником, и выполнить новую попытку подсадки.
- После переноса эмбрион остается в катетере. В этом случае питательная среда с ним набирается вновь, а повторная процедура проводится стандартным образом.
В некоторых случаях пациентка не может расслабиться, что является обязательным условием для успешного переноса. Чтобы снять напряжение, применяется безвредный кратковременный наркоз.
Почему нежелательно делать ЭКО в стрессовом состоянии?
Стресс способен стать серьезным препятствием на пути к наступлению беременности. В то же время женщина, готовящаяся к ЭКО, не должна принимать сильные антидепрессанты.
Лучше всего обсудить с опытным психологом или психиатром, как поступить в подобной ситуации, и какие успокаивающие средства станут наиболее безопасными
Также важно уточнить заранее, что можно принимать от стресса во время беременности
Может ли эмбрион выпасть из матки после процедуры?
Специалисты медицинского центра «Medical Plaza» всегда предупреждают пациенток о том, что подобное полностью исключено. Женские репродуктивные органы устроены таким образом, чтобы обеспечивать эмбриону полную безопасность внутри маточной полости.
Что такое спайки, как они появляются в матке и фаллопиевых трубах, каковы симптомы?
Спайки – это одна из разновидностей рубцов, их образованию обычно предшествует травма, воспалительный процесс или хирургическое вмешательство. Они состоят из соединительной ткани и могут иметь вид перепонок или тяжей. Спаечный процесс приводит к сращению тканей или стенок какого-либо органа или органов, которые в норме должны быть разделены. Вероятные причины спаек:
- операции в брюшной полости;
- кесарево сечение;
- инфекции органов репродуктивной системы;
- воспаление матки и ее придатков;
- травма живота;
- аппендицит и перитонит;
- эндометриоз.

Спайки нарушают нормальную анатомию органов малого таза и могут мешать зачатию и процессу вынашивания плода. Некоторые воспалительные заболевания, вызывающие образование спаек, имеют не выраженную симптоматику или протекают совсем бессимптомно, поэтому обнаружение спаечных изменений может стать неожиданной диагностической находкой.
В зависимости от строения врачи делят спайки на несколько видов:
- пленковидные (имеют тонкую структуру и состоят только из соединительной ткани);
- толстые (содержат кровеносные сосуды, поэтому нуждаются в дополнительных методах лазерной или электрокоагуляции при их удалении);
- полосообразные (имеют вид не тяжей, а полосок различной ширины);
- плоские (образуются при сращениях большой площади).

Возможности гипербарической оксигенации

Что такое гипербарическая оксигенация?

Гипербарическая оксигенация — это метод лечения, при котором пациент находится в специальной камере, наполненной кислородом под давлением, что позволяет увеличить количество кислорода, поступающего в организм.
Как гипербарическая оксигенация может помочь в подготовке к ЭКО?
Гипербарическая оксигенация стимулирует рост кровеносных сосудов и укрепляет иммунную систему. Это может быть особенно полезно для женщин, подготавливающихся к ЭКО, так как это поможет улучшить кровоснабжение эндометрия и улучшить его состояние, что может увеличить шансы на успешное внедрение эмбриона.
Как проходит процедура гипербарической оксигенации?
Процедура гипербарической оксигенации проводится в специальной камере, где пациент находится в течение нескольких часов. Камера заполняется кислородом под давлением, что позволяет увеличить количество кислорода в крови пациента. Процедура безопасна и не вызывает боль.
Как выбрать провайдера гипербарической оксигенации?

При выборе провайдера гипербарической оксигенации, необходимо обратить внимание на опыт и квалификацию медицинского персонала, уровень технического оборудования и соответствие процедуры международным стандартам. Стоимость процедуры также может варьироваться в зависимости от провайдера и региона
Влияет ли криоконсервация на дальнейшее развитие ребенка?
Многие семейные пары опасаются, что криоконсервация приведет к нарушениям развития малыша. Опасения вызваны пребыванием зародыша длительное время в неестественной среде. Однако многочисленные исследования показали, что дети, зачатые после подсадки размороженных эмбрионов, не отличаются от родившихся при естественном зачатии.
Напротив, использование размороженного биоматериала позволяет сократить вероятность рождения ребенка с генетическими отклонениями. Это достигается благодаря тщательному отбору наиболее качественного материала и контролю над делением клеток. Эмбрионы полностью сохраняют генетику родителей.
Как проводится криоконсервация?
Для криоконсервирования выбирают эмбрионов, достигших стадии бластоцисты. Такой зародыш лучше имплантируется после размораживания. Эмбрионы обрабатывают криопротектором, предотвращающим гибель биоматериала, и помещают в специальные контейнеры в виде трубочки. В одной трубке могут находиться 5–6 оплодотворенных яйцеклеток.
Емкости размещают в криобанке и замораживают. Существуют 2 типа заморозки:
- Медленная. Данная методика предусматривает регулируемое замораживание материала. Его охлаждают со скоростью 1 градус в минуту. При определенной температуре их погружают в жидкий азот. Данный метод имеет высокие показатели гибели эмбрионов, поскольку во время охлаждения увеличивается риск образования кристаллов льда внутри бластоцисты.
- Быстрая (витрификация). Более дорогой, но результативный способ заморозки. Зародыши замерзают, но клетки не кристаллизируются. В бластоцисте образуется желеподобная субстанция, сохраняющая жизнеспособность эмбриона.
Длительность хранения биоматериала в криобанке зависит от желания пары. Зародыши могут храниться в охлажденном состоянии от нескольких недель до десятков лет.





































